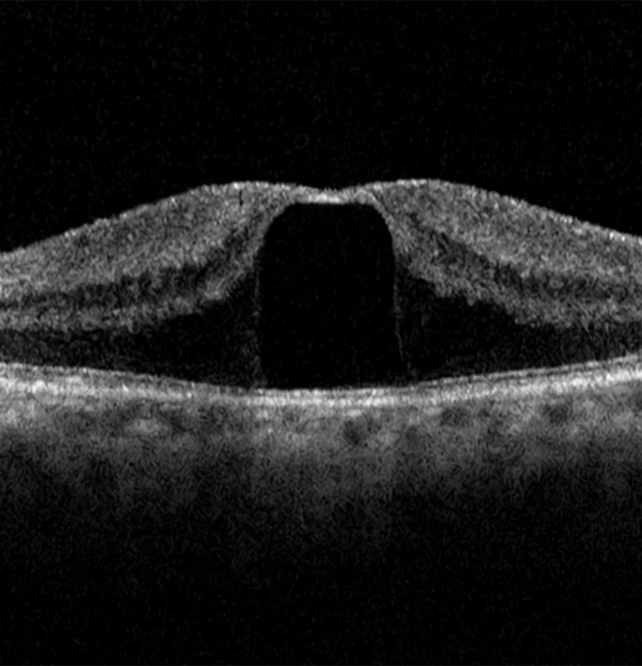

As a result of increase in blood sugar levels, small blood vessels of the retina can leak and leads to accumulation of Fluid under the retina known as MACULAR OEDEMA.
The main symptoms are blurring of vision or Metamorphopsia.
Diagnosis :- Indirect ophthalmoscopy , OCT (Optical coherence tomography), FFA (fundus fluorescein angiography).
Treatment :–Laser photocoagulation, Intravitreal Antivegf/ Steroids and surgery (Vitrectomy) in Advanced cases is also required.


Main causes of this condition are Raised blood pressure, Raised cholesterol levels, Diabetes and it is more common in old age groups but can also occur in young cases.
Most common symptom is blurring of vision.
The early the diagnosis is made better are the outcomes
Diagnosis :- Indirect ophthalmoscopy , OCT (Optical coherence tomography), FFA (fundus fluorescein angiography).
Treatment :– Laser photocoagulation, Intravitreal Antivegf/ Steroids and surgery (Vitrectomy) in Advanced cases is also required.
DRY ARMD - :This condition is commonly seen in elderly patientsin which there is deterioration of central part of retina known as Macula ( as name suggests degeneration of the macula) and it leads to loss of vision along with distortion of images as pt visualizes straight lines a wavy.
WET ARMD -: Also commonly known as CNVM, characterized by formation of new blood vessels at macula, which are very fragile and leak causing accumulation of blood at macula further leading to loss of vision.
Diagnosis :- Detailed fundus evaluation, OCT (Optical coherence tomography), FFA (fundus fluorescein angiography).
Treatment :–Intravitreal Antivegf agents.


It is a serious eye condition which causes significant vision loss.
Early signs of Retina Detachment are sudden appearance of Floaters or Flashes or both and Curtain falling or moving across the visual field.
In case any of the above symptoms appear the patient should immediately consult ophthalmologist.
It occurs when fluid accumulates under the retina through a hole or a break which lifts the retina and separates it from underlying layers.
Diagnosis :- Detailed evaluation of the Retina
Treatment :–treatment is only surgical (Scleral Buckle or Vitrectomy)
At Khanna Eye Centre we are equipped with Latest technology and experienced Surgeons to tackle these conditions and to perform surgeries for above conditions.
Macula is the central part of the Retina, due to certain factors that is aeging changes, macular oedema or trauma there may develop a defect in thr central part called “Macular Hole”.
In case any of the above symptoms appear the patient should immediately consult ophthalmologist.
It occurs when fluid accumulates under the retina through a hole or a break which lifts the retina and separates it from underlying layers.
Diagnosis :- Retina Evaluation , OCT (Optical coherence tomography).
Treatment :–Surgical treatment with Pars Plana Vitrectomy performed as early as possible.
CSCR (Central Serous Chorioretinopathy)
We are equipped with latest sutureless Micro Vitrectomy system for Retinal Detachment, Diabetic retinopathy, Vitreous Hemorrhage, Macular hole, Dislocated Lens and all other retinal conditions